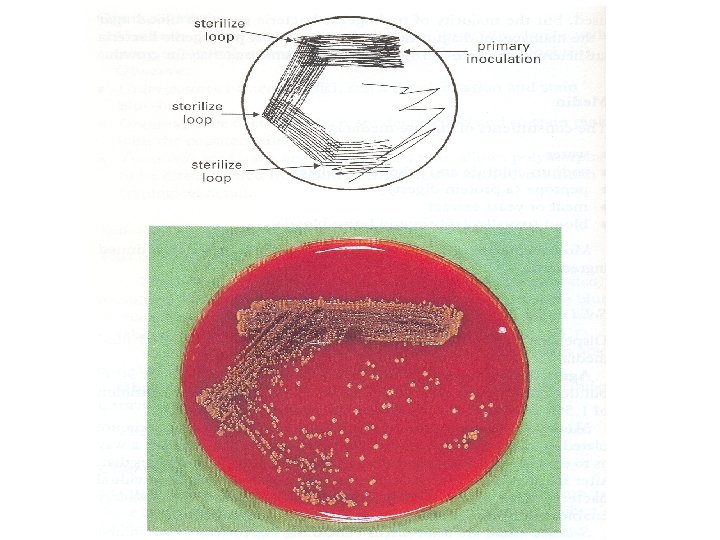
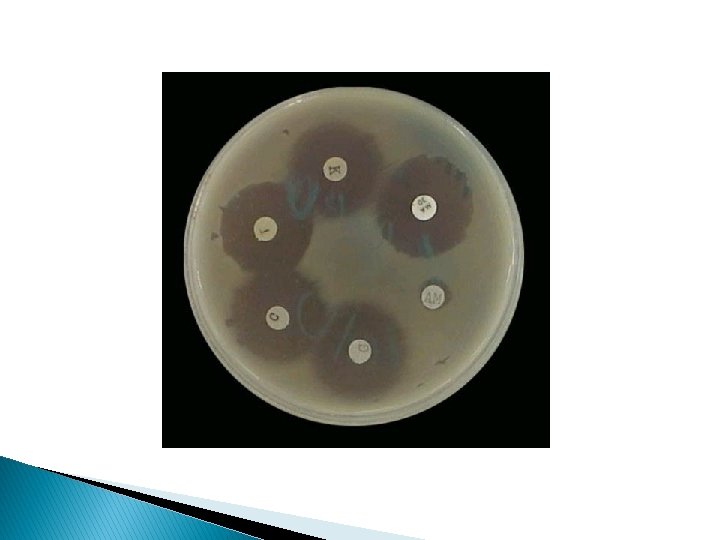

Culture Methods Culture Methods Indications for culture Isolate



























- Slides: 27

Culture Methods

Culture Methods Indications for culture � Isolate bacteria in pure cultures. � Demonstrate their properties. � Obtain sufficient growth for preparation of antigens & for other tests. � Typing bacterial isolates. � Antibiotic sensitivity. � Estimate viable counts. � Maintain stock cultures.

Types of culture methods �Streak culture or surface plating �Lawn or carpet culture �Stroke culture �Stab culture �Pour plate method �Anaerobic methods of culturing bacteria

Aseptic technique

Streak Culture (Surface Plating) �Routinely �Platinum employed for isolation / Nichrome loops

Procedure �A platinum loop is charged with specimen. �Sample is spread over small area to form a primary inoculum �Sample distributed thinly over plate by streaking with loop in a series of parallel lines �On incubation v Primary: confluent growth v Secondary lines: isolated colonies

Lawn or Carpet Culture � Uniform surface growth � Bacteriophages � Antibiotic typing sensitivity testing (Disc method) � Preparation of bacterial antigens & vaccines

Procedure � Flooding the surface of plate with a liquid culture and pipetting off excess inoculum from surface. � Applying a swab soaked in bacterial suspension.

Stroke Culture � Tubes containing agar slopes � For slide agglutination & other diagnostic tests.

Stab Culture �By puncturing a suitable medium with a long, straight charged wire. �For gelatin liquefaction, stock cultures & motility


Pour Plate Method � 1 ml of appropriately diluted inoculum is added to 15 ml of molten agar and poured on Petridish. � Colonies appear through out the depth of medium. � Used to estimate viable count, recommended method for quantitative urine cultures.

Liquid Culture �Inoculated syringes. �For by a charged loop, pipette or blood cultures & sterility testing. �Preferred where inocula contains antibiotics and other inhibitory substances, which are rendered ineffective by dilution in medium �Continuous culture methods: bacterial yield enhanced by agitation, aeration, addition of nutrients, removal of toxic metabolites

Anaerobic Culture Methods Anaerobic condition can be achieved by 1. Exclusion of oxygen or production of Vaccum 2. displacement of O 2 with other gases. 3. absorption of O 2 by chemical or biological means 4. reduction of O 2

Vaccum method �Vaccum �Some �Fluid dessicator oxygen is always left behind culture boil over and media gets detached from plates

Displacement Method �Displacement of O 2 with gases like H 2 , N 2 , He or CO 2. �Rarely produces complete anaerobiosis. e. g. Candle jar �Inoculated plates are kept in airtight container with a lighted candle in it �Burning candle uses oxygen inside before it is extinguished

Chemical or Biological Method � Alkaline pyrogallol ( pyrogallic acid in Na. OH) absorbs O 2. � Pyrogallic acid reacts with Na. OH and absorbs Oxygen during the reaction. � Rosenthal method - Mixture of chromium & Sulphuric acid or Yellow phosphorous. � Mc. Intosh - Fildes’ Jar. � Gaspak

Mc. Intosh - Fildes’ Jar � Most reliable & widely used anaerobic method � Complete anaerobiosis

� Stout glass or metal jar with a metal lid that can be clamped airtight � Lid has two tubes with taps, one inlet for gas and another outlet � It also has two terminals � connected to electrical supply � Leading from the terminals on underside of lid a small grooved porcelain spool wrapped with palladinised asbestos.

Procedure � Outlet tube connected to Vaccum pump and inside evacuated. � Outlet tap closed and inlet connected to hydrogen supply and jar is filled with hydrogen � Electricity started to heat asbestos, which acts as catalyst for combination of hydrogen with left over oxygen in jar to form water � This method ensures complete anaerobiosis � Disadv: risk of explosion

Gaspak � Method of choice for preparing anaerobic jars. � Commercially available as disposable envelope, containing chemicals which generate H 2 , CO 2 with the addition of water. � Reduced Methylene blue is used as indicator. Remains colorless anaerobically but turns blue on exposure to O 2

Reduction of Oxygen � Using reducing agents like 1% glucose, 0. 1% thioglycollate, 0. 1% ascorbic acid and 0. 05% Cysteine. � Smith –Noguchi medium: Fresh animal tissues, Rabbit kidney, spleen, testes and heart.

Robertson’s Cooked Meat Medium � most widely used fluid medium � Fat free minced cooked meat in broth, with a layer of sterile Vaseline over it. � Permits growth of strict anaerobes and also indicates proteolytic (black) and Saccharolytic (red) activity. Thioglycolate medium � with hemin and vitamin K used for anaerobic and microaerophilic bacteria

Methods for isolating pure cultures 1. Surface plating method. 2. Enrichment, selective and indicator media 3. Pre-treatment of specimens with bactericidal agents: Sputum for tubercle bacilli 4. Obligate aerobes and anerobes cultivated under aerobic and anaerobic condition- Shake culture in Veillon tubes.

Methods for isolating pure cultures 5. Incubation at different temperature depending on temperature requirement 6. Vegetative and spore forming bacteria seperated by heating at 80ºC 7. Separation of motile and non motile bacteria by Craigie’s tube. 8. Filtration